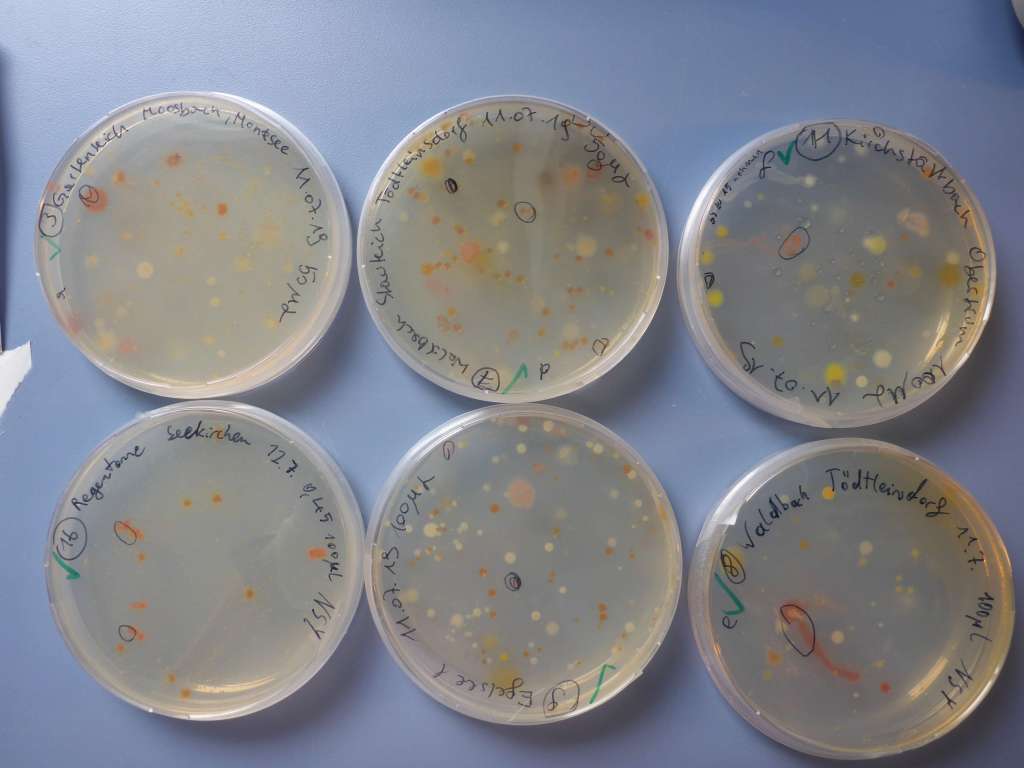

Unsere beiden Praktikantinnen Sophia und Ingrid haben während ihrer Zeit bei uns versucht, dem Geheimnis auf die Spur zu kommen, wo sich in unserer Umgebung Bakterien unserer Gattung Aquirufa verbergen. Dazu haben sie aus 16 Gewässern Proben genommen. Diese wurden wie damals in der Schule filtriert und auf Agarplatten ausgestrichen, diesmal allerdings unter einer sterilen Werkbank. Unter den vielen erhaltenen Kolonien haben sie dann die ausgewählt, die dem Rot unserer Aquirufa am meisten ähneln und haben sie in mit einem Zahnstocher (sterilisierten 🙂 ) in eine Nährlösung übertragen. Von dort haben sie vielversprechende Kulturen wieder auf Agarplatten ausgestrichen. Von den fast 100 erhaltenen Flüssigkulturen haben sie mit Ulli zusammen PCR gemacht, das heißt die Erbsubstanz wurde vervielfältigt und dann gleich zum Sequenzieren weggeschickt. Wir hatten Glück und am Anfang ihrer letzten Woche kamen tatsächlich die 92 Sequenzen per email zu uns. Erstmal war es für sie etwas überrraschend, dass diese Sequenzen, von denen immer alle reden 🙂 , wirklich nur aus einer Aneinandereihung von vier Buchstaben bestehen. In ihrem Fall waren das ca. 800 der insgesamt 3 Millionen, die die Aquirufas ungefähr besitzen. Sophia und Ingrid machten sich sofort ans bearbeiten, das heißt überprüften die Qualität und verglichen die Sequenzen mit denen aus Datenbanken. Das war eine ganz schöne Arbeit, aber die beiden haben das wirklich gut gemacht. Am Ende der Analysen stand fest, sie hatten 16 Aquirufa Stämme erhalten. 9 davon haben wir ausgewählt, die werden wir im Labor aufreinigen und zum Schluss schauen, ob neue Arten dabei sind. Als Nebenprodukt hatten die zwei noch andere interessante Bakterien entdeckt, aber das ist wieder ein anderes Kapitel 🙂

Wir waren tasächlich auch sehr überrascht, dass das so gut funktioniert hat. Die beiden konnten unter den wahrscheinlich hunderten von Bakterienarten, die auf den Agarplatten gewachsen waren, viele Aquirufas aufgrund ihrer charakteristischen Farbe herausfischen. Bestätigt hat sich ausserdem unsere Vermutung, dass es sich um sehr weit verbreitete typische Gewässerbakterien handelt. Inzwischen interessieren sich übringens nicht nur Koreaner dafür, noch stärkere Konkurrenz haben wir jetzt aus Taiwan 🙂 , aber das ist wieder ein neues Kapitel, fast ein ganzes Buch 😉 , darüber wird im Herbst berichtet, wenn wir mehr wissen.
Während Sophia und Ingrid bei uns im Labor waren, hatten wir Besuch von zwei Gastwissenschaftlern aus Japan, die auch mit Bakterien arbeiten. Die zwei waren über die Tatsache, dass zwei sechzehnjährige Schülerinnen im Labor arbeiten und Bakterien isolieren sehr erstaunt. Sie haben während ihres Aufenthaltes mehrmals davon geredet und immer wieder nachgefragt, ob wir wirklich mit Schüler/innen neue Bakterienarten beschreiben 😉 .